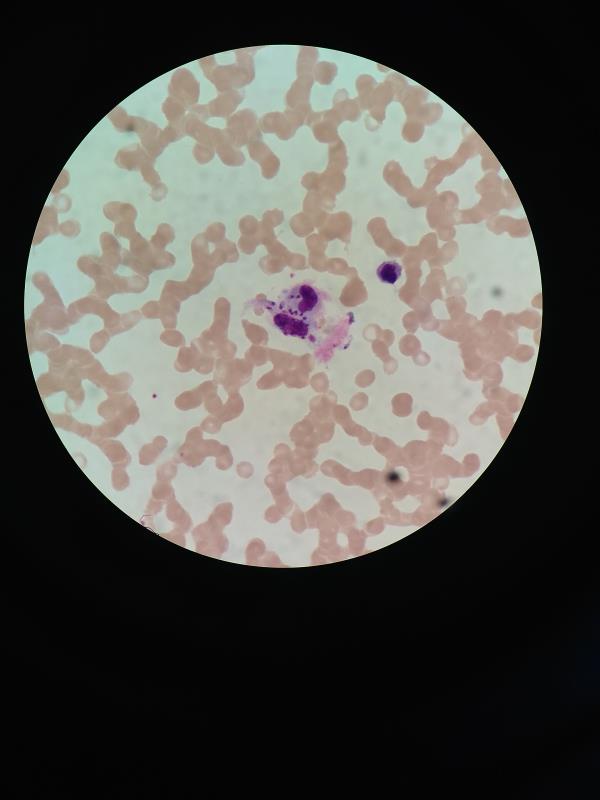

2月26日,来自华县的患者陈某,因发热20余天,在当地医院医治无果,遂来我院就诊。医院发热门诊经过专业检查,排除新冠肺炎后,以“发热原因待诊,三系细胞减少查因”之初步诊断,将患者收住老年病、血液病科。
赵挺副主任医师和李宝娟主治医师根据患者临床表现,完善相关检查,给予对症治疗后,患者体温没有明显下降,临床症状未见改善。
由于发热时间较长,患者受到精神上和身体上双重折磨,时常以泪洗面,感觉自己无药可救。每天查房时,看着病人痛苦的样子,两位主管医师决心一定要找出折磨患者的原因。但凭借多年的临床经验,她们知道,此患者的发热没有那么简单。风湿热、肿瘤热、血液病、病毒感染、结核病,到底是什么?这些问号每天在两位主管医师脑海中盘旋,可是随着检查结果的一一汇报,一次次希望变成失望,两位医师的眉头也越皱越紧。
随着疾病的变化,该患者出现电解质紊乱、低蛋白血症,血常规提示三系细胞进行性降低,甚至出现了粒缺,病情十分危重。给予积极对症治疗的同时,周淑亚主任带领科室人员查找发热原因,护士长陶燕燕带领护士团队加强对患者的护理及心理疏导,树立他战胜病魔的信心。
这时,骨髓诊断室李瑾老师在该患者的骨髓中看到了一些特殊的、类似“小瓜子”的东西,怀疑是“利杜氏小体”,这个猜测给了周主任他们一个思路。

“利杜氏小体”是利什曼病中骨髓像所特有,可是,利氏曼病有明显的流行病学特征,常见于我国甘肃省及新疆维吾尔自治区,白蛉作为媒介,故该病常出现在畜牧人群中。陕西省虽属于流行区,但病例少见,该患者的流行病学史并不成立。经过科室人员查阅相关资料,再次讨论病情及分析骨髓片,大家一致认为,镜下看到的就是“利杜氏小体”。
至此,历时一周多的时间,终于明确诊断:内脏利什曼病,又称黑热病。这些镜下的“小瓜子”就是罪魁祸首。得到准确答案的患者及其家属激动地留下泪水。目前,该患者已经转危为安,病情逐渐好转。
近年来,随着人口的流动及疾病的发展,很多少见及罕见的地方病也逐渐出现在临床病例中,成为非高发区的常见病。老年病、血液病科此次的诊治案例充分说明,在缺乏明确流行病学史的前提下,如何准确、快速查找病人的发病原因,需要主管医生缜密的诊疗思路,以及科室成员的团结协作,更需要从医人锲而不舍的钻研精神。此病例也标志着渭南市中心医院老年病、血液病科临床诊治水平和骨髓实验室诊断能力迈入了新的发展阶段。